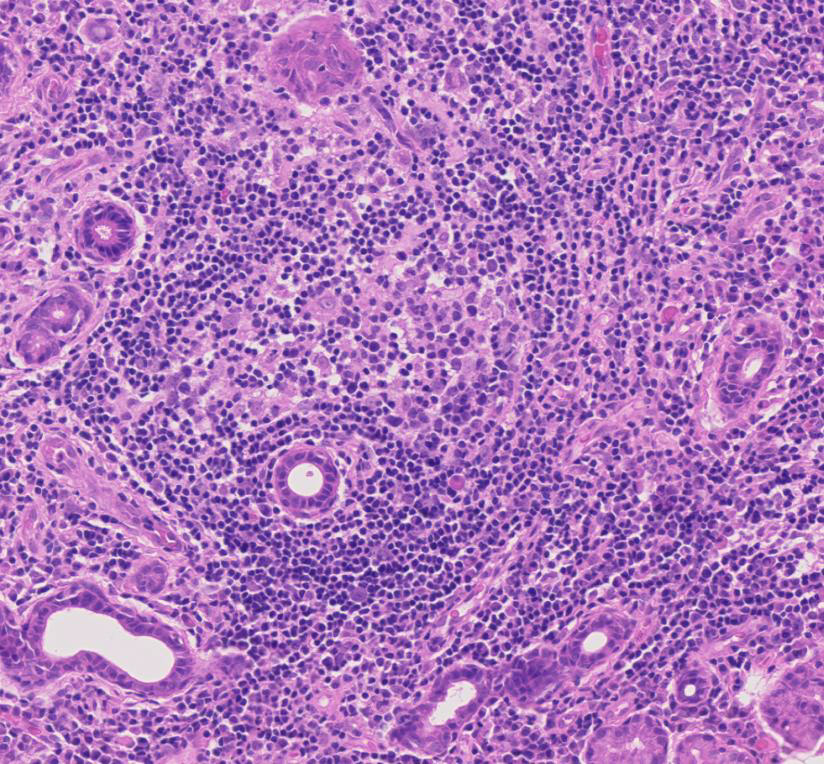

DOI: https://doi.org/10.4414/smw.2015.14168
Sjögren’s syndrome (SS), clinically and histologically described by the Swedish ophthalmologist Henry Sjögren in 1933, is an autoimmune disorder that mainly affects lachrymal and salivary glands, resulting in dryness of the eyes (keratoconjunctivitis sicca) and mouth (xerostomia). The organ-specific pathology is caused by local inflammation and progressive loss of the glandular parenchyma [1]. In 50%–60% of cases this disorder is associated with other systemic autoimmune diseases, such as rheumatoid arthritis or systemic lupus erythematosus. In those cases, SS is denominated secondary [1, 2].

Figure 1
Haematoxylin and eosin staining of salivary gland biopsy section showing several periepithelial mononuclear cell infiltrates, i.e. focal lymphocytic sialoadenitis.
Primary SS (pSS), which occurs in the absence of these other conditions, has a higher frequency in female patients (9:1) and a prevalence of 0.5% in the general population, making SS one of the three most frequent autoimmune diseases [1, 3–5].
PSS is characterised by, but not limited to, secretory dysfunction. One third of the patients exhibit systemic extraglandular manifestations, whose development and onset varies during the disease progression [2, 6]. Therefore, the diagnostic process and the clinical management of pSS often requires the combination of several areas of specialisation and benefits from combined clinical teams of rheumatologists, ophthalmologists and oral medicine specialists.
Extraglandular manifestations of pSS include cutaneous vasculitis, peripheral neuropathy, renal tubular acidosis, pulmonary involvement, lymphoproliferative disease and immunological abnormalities, such as lymphopenia, anaemia or thrombocytopenia [7, 8]. Immunological findings are also observed in pSS, such as the presence of anti-Sjögren’s-syndrome-related antigen A and B autoantibodies (antiSSA/Ro and SSB/La), hypergammaglobulinaemia and low complement levels (C4) [9].
In approximately 5% of pSS patients the disease evolves towards lymphoma, conferring a higher mortality risk in pSS as compared with the normal population [10]. Patients with pSS have a 16 to 44 times increased risk of developing lymphoma. Histologically, the malignancies are predominantly mucosa-associated lymphoid tissue (MALT) lymphoma ⁄ non-Hodgkin’s lymphoma (NHL) that form in extranodal sites, mainly within the acquired MALT present in affected major salivary glands [11, 12]. However, other forms of B cell lymphoma, such as diffuse large B cell lymphoma, are also observed.
Histologically, pSS is characterised by the formation of periepithelial mononuclear cell infiltrates (fig. 1). The aggregates preferentially form in the exocrine glands: salivary glands, lachrymal glands and exocrine pancreas. The histological lesions typical of SS occur in both major and minor salivary glands. Although the major salivary glands, in particular parotid glands, are often the sites of formation for the B cell lymphoma, in the majority of cases, it is not justifiable to obtain a major salivary gland biopsy owing to its inconvenience to patients and the possible complication of salivary fistula, scarring and facial nerve damage [13]. Few groups with a specific interest in SS routinely perform major salivary gland biopsy, which, however, in experienced hands, has a rather acceptable safety profile. Nonetheless, minor salivary gland biopsy can be obtained in a day-care facility with minimal invasiveness and discomfort [14]. Studies looking at the concordance of the histological lesions between the major and minor glands are reassuring, showing similar diagnostic sensitivity and specificity [15]. Nonetheless, the predominance of lymphoepithelial lesions (areas of lymphocytic infiltration of the duct that result in atrophy of the columnar ductal epithelium and proliferation of the basal epithelial cells [fig. 2]) and the detection of better-organised germinal centres in the former in the major but not minor salivary glands has to be acknowledged [16–18].

Figure 2
Haematoxylin and eosin staining of labial salivary gland biopsy with evident lymphoepithelial lesion.


Figure 3
Immunohistochemistry staining for CD20 and CD3 in sequential sections of a labial salivary gland sample showing a large, segregated focus with a predominant B cell infiltrate.
In the early stages of the disease, small focal lymphocytic aggregates form around the interlobular and intralobular ducts. The large diffuse infiltrate then spreads into the parenchyma, resulting in the loss of tissue architecture and atrophic involution of the acini [19]. Parenchymal and ductal alterations can be observed in the affected glands including reduction of the acinal parenchyma and hyperplasia of the lining cells of the intraglandular ducts [1, 13, 20]. Accumulation of hyaline material is also found in the lumen of altered ducts and around blood vessels [13, 19]. Small foci consist predominantly of plasma cells with a smaller lymphocytic component that is distributed throughout the foci. Larger foci are mainly composed of lymphocytes with fewer macrophages and plasma cells. A discrete plasma cell component can be observed at the periphery of the larger foci [13].
Activated CD4+ T cells predominate in small aggregates and decrease in severe lesions. B cell infiltration predominates in the larger foci (fig. 3) [20, 21]. Accordingly, the T/B cell ratio is negatively associated with the degree of inflammation [20]. On the other hand, the percentage of CD8+ T cells and natural killer (NK) cells does not significantly change with lesion severity [20]. Regulatory T cells (Tregs) are also found in SS lesions and their frequency varies according to lesion severity, with the highest frequency found in intermediate size lesions [21].
In approximately 20%–25% of SS patients the salivary gland aggregates are organised into segregated T and B cell areas, and are characterised by the formation of areas of active B cell proliferation and follicular dendritic cell networks within areas of active B cell proliferation, defined germinal centre (GC)-like structures (fig. 4) [22]. Salivary gland lymphoid organisation and GC formation is accompanied by the ectopic production of the lymphoid chemokines CXCL13, CCL21 and CXCL12 [17, 18], which localise, within the aggregates, in discrete areas resembling the lymphoid organisation observed in secondary lymphoid organs [23–26]. Increased local and systemic (serum and saliva) levels of CXCL13 correlates with xerostomia [47] and we previously demonstrated that in lymphoid aggregates the level of CXCL13 or CCL21 correlates with the degree of organisation of the foci [17, 18].
A large body of literature has highlighted the potential role for the GC-like structures present in the salivary glands in sustaining the process of B cell affinity maturation of autoreactive clones. Indeed, the progressive acquisition of lymphoid features by the salivary gland inflammatory aggregates associates with the local expression of activation-induced cytidine deaminase (AID), the enzyme instrumental in B cell affinity maturation [17, 18]. Moreover, a positive correlation between the persistence of the GC-like structures and the development of B cell lymphoma has been suggested [27].
The large spectrum of manifestations typical of SS has provided a major challenge for the definition and validation of unifying classification criteria [6]. In 1993, the European Study Group on Diagnostic Criteria for SS proposed a set of six items including two subjective and four objective criteria [28]. These items included: ocular symptoms; oral symptoms; ocular signs; presence of focal lymphocytic sialoadenitis (FLS); instrumental evidence of salivary gland involvement; and presence of autoantibodies (anti-SSA/Ro and/or anti-SSB/La). The presence of any four of the above mentioned criteria are indicative of pSS in the absence of associated autoimmune disease [28]. The main criticism raised to these criteria was the potential inclusion of patients with no evidence of sialoadenitis and no presence of autoantibodies [29]. In 2002 Vitali et al. revised these criteria, making the presence of a histological diagnosis of SS or the presence in the serum of anti-SSA/Ro and/or anti-SSB/La antibodies mandatory for the diagnosis of pSS [29].
Figure 4
Germinal centre-like structure in a primary Sjögren’s syndrome salivary gland.
In 2012, the Sjögren’s International Collaborative Clinical Alliance (SICCA) published the first set of criteria approved by the American College of Rheumatology (ACR). According to these, the classification of an individual as a pSS patient is based exclusively on the presence of objective criteria, which include the detection of serum anti-Ro/SSA and/or anti-La/SSB antibodies, or positive rheumatoid factor (RF) and antinuclear antibody (ANA); a positive salivary gland biopsy exhibiting a focal lymphocytic sialoadenitis with a focus score ≥1 or the presence of keratoconjuctivitis sicca [6]. Two out of three of these criteria are required for disease diagnosis. As a result of overlapping clinical features or interference with criteria tests, the following are considered exclusion criteria for patient classification: history of head and neck radiation treatment, hepatitis C infection, acquired immunodeficiency syndrome, sarcoidosis, amyloidosis, graft versus host disease, IgG4-related disease [6]. Several criticisms of these proposed new criteria have been made [48]; however, Rasmussen et al. have recently demonstrated concordance between the AECG and ACR sets of classification criteria when applied to the same cohort [30].
A summary of both the European and American criteria can be found in table 1.
Although the classification criteria have been designed for clinical studies, they are often used in the clinical practice to support the diagnostic process. In this context, the performance of a salivary gland biopsy and the relevant histological examination is critical for a number of patients who present with negative extractable nuclear antigen (ENA) antibodies [31]. In those cases a positive histological assessment is required to substantiate the clinical diagnosis of pSS [29].
| Table 1:European and American classification criteria 2002. |
| European Classification criteria for primary Sjögren’s Syndrome (2002) [29] |
| I Ocular symptoms(at least one positive answer out of 3 questions)II Oral symptoms(at least one positive answer out of 3 questions)III Ocular signs(positive to result to Schirmer’s I test or/and Rose bengal score)IV Histopathology(focus score ≥1)V Salivary gland involvement(at least one positive result in the following tests: unstimulated whole salivary flow, parotid sialography, salivary scintigraphy)VI Autoantibodies(presence of anti-Ro/SSA or/and anti-La/SSB) |
| For classification of primary Sjögren’s Syndrome patients should present: Any four of the six items above, including either item IV or item VI Any three of the four objective criteria (items III, IV, V and VI) |
| American College of Rheumatology classification criteria for primary Sjögren’s Syndrome (2012) [6] Patients should present at least two of the following three objective criteria |
| ‒ Presence of serum anti-Ro/SSA and/or anti-La/SSB antibodies, or positive rheumatoid factor (RF) and antinuclear antibody (ANA) |
| ‒ Positive salivary gland biopsy exhibiting a focal lymphocytic sialoadenitis with a focus score ≥1 |
| ‒ Presence of keratoconjuctivitis sicca |
The importance given to the histological examination of the salivary gland biopsy in both diagnostic criteria sets has prompted the pharmaceutical industry to use salivary gland histology as outcome measure in clinical trials. This has brought to the broader attention of both the rheumatology and oral medicine communities the need to evaluate the reliability, stability and performance of the current histological criteria as diagnostic, prognostic and outcome tools.
In this review we will not focus on the different techniques used to obtain salivary gland tissue (minimal invasive biopsy, wedge biopsy, sicca protocol [32]), though it is important to highlight that appropriate tissue collection and embedding is central to the histological assessment. There is still a debate on the quantity of tissue, cutting levels and histological components to be included in the histological analysis. While consensus has not been reached yet, a series of initiatives are in place to establish new recommendations for the use of histology as clinical biomarker in SS diagnosis and clinical trials [49].
The classical method for scoring SS biopsies relies on the Chisholm and Mason criteria (1968). This grading system (four grades) relies on the detection in the gland of focal lymphocytic and/or diffuse lymphocytic infiltration (table 2). The presence of more than 50 periductal lymphocytes (histiocytes and plasma cells) in 4 mm2 of salivary gland tissue is used as criteria for the definition of a focus [1].
The focus score was elaborated by Greenspan in 1974 as extension of the Chisholm and Mason classification. According to its definition, the identification of focal lymphocytic sialoadenitis (FLS) is followed by the quantification of the number of foci per 4 mm2 of tissue section adjacent to normal parenchyma [13]. Given the heterogeneous distribution of the inflammatory infiltrate and glandular damage, analysis of four to seven glands from each patient is suggested in order to obtain a reasonably sized sample [13].
The focus score has been validated as a histological index of severity of the salivary gland involvement in pSS. A series of manuscripts have correlated the presence of high focus scores with indices of local or systemic disease activity. The presence of a higher focus score has been found to correlate with acinar damage [13], presence of anti-SSA/B serology (12 times higher among those with focus score ≥1 than among those with focus score <1 or without FLS; 95% confidence interval [CI]: 9.3‒15.5) and the presence of specific extraglandular features such as Raynaud’s phenomenon, vasculitis, lymph node or spleen enlargement and leucopenia [33]. A focus score ≥1 has also been found to correlate with positive RF serology, high ANA titres and IgG concentrations, the presence of keratoconjunctivitis sicca and low unstimulated but not stimulated salivary flow rates [14, 34]. More recently, Risselada et al. (2013) established that a high focus score (≥3) has a significant predictive value for the development of non-Hodgkin B cell lymphoma [35].
Whilst the focus score has been proven as a functional diagnostic and prognostic tool, it presents obvious limitations. First, the stability of the focus score in repeated biopsies over a long period of time is not fully established. Costa et al. (2014) reported a study in which minor salivary gland biopsies, from the TEARS (Tolerance and Efficacy of Rituximab in Primary Sjögren’s syndrome) project, were analysed with a standard blinded assessment by two different pathologists at 2-month interval. The analysis included the measurement of FLS and detection of GC-like structures [36]. The interobserver variability comparison revealed poor agreement for the detection and calculation of focus score and detection of FLS, lack of concordance for the presence of duct dilation and (less for) fibrosis. Surprisingly, in 12.6% of the cases the second evaluation by trained pathologists led to a diagnosis change [36], thus supporting the need for the use of a specialised trained pathologist and not a general histology service for salivary gland biopsy analysis.
Whilst the studies mentioned above, in particular the correlation between a higher focus score and the development of lymphoma, suggest stability of the histological lesions over a period of time, this has not been proven in large cohorts. This point raises a series of concerns about the choice to introduce a placebo group when performing longitudinal assessment of salivary gland biopsies in interventional clinical trials. As this appears redundant on the base of current observations on stability of the aggregates, it is general opinion that the lack of large longitudinal studies is required to substantiate the decision to omit the placebo group, in particular when the intervention is in its early phases of development and the histological changes are used a measure of outcome.
Classically the focus score assessment requires only a single cutting level analysis, potentially introducing a critical bias in the sample analysis. A study looking at this bias, extending the examination to three different cutting levels (as opposed to a single level) indeed demonstrated improvement in the diagnostic performance of the AECG classification, especially in biopsies with a baseline focus score between 1 and 2 [37]. The requirement for the use of multilevel examination, in particular during clinical studies, is under revision [49].
The focus score, whilst giving an idea of the extent of the cellular infiltrate, fails to provide discrete data on the foci size; indeed, for larger or confluent foci a focus score of 12 is arbitrarily used [13]. This aspect, while not critically determinant for the histological diagnosis of SS, could represent a problem for the use of the focus score as an outcome measure in clinical trials in which subtle changes in foci size might not be accurately reported in the focus score. The introduction of additional measurements such as average of focus area, area of lymphocytic infiltration and evaluation of the degree of organisation to augment the information provided by the simple focus score is currently debated in the SS community.
| Table 2: Grading method introduced by Chisholm and Mason in 1968. | |
| Grade | Lymphocytes and plasma cells per 4 mm2 |
| Absent | |
| 1 | Slight infiltrate |
| 2 | Moderate infiltrate or less than one focus* |
| 3 | One focus |
| 4 | More than one focus |
| * Focus = an aggregate of 50 or more lymphocytes, histiocytes and plasma cells [50]. | |
Whilst giving a clear representation of the extent of the inflammatory aggregate, the focus score fails to provide information on its organisation. The focus score does not require quantification of the presence of GC-like structures or the evaluation of the aggregation of lymphocytes in segregated T and B cells areas. Indeed, the focus score can be performed on basic haematoxylin/eosin-stained tissue without requiring further immune staining of the sample [13].
The presence of histologically detectable GCs (25.1% [±5.0% standard deviation]) in pSS patients has been found to correlate with the presence of a higher focus score (1.25 points higher) [38]. In the same study, a correlation between the presence of GCs with the levels of local and systemic proinflammatory mediators has also been established [38]. More recently, Theander et al. have reported the strong negative correlation (99% negative predictive value) between the absence of GC detection and development of B cell lymphoma [39], thus highlighting the value of reporting the presence of GC-like structures in the histological report alongside the focus score [40]. This information provides both patients and clinicians with a stratification tool to identify patients who will require more frequent monitoring. Interestingly, the data provided so far focuses only on histological identification of GC like structures on haematoxylin/eosin-stained samples. In minor salivary glands, where full lymphoid organisation is not often achieved by the foci, the detection of GC-like structures appears to increase with the use of CD21 staining to detect follicular dendritic cell networks [17, 18]. However, it is not clear whether the introduction of CD21 staining will in turn decrease the negative predictive value of the absence of GC-like structures in relationship to lymphoma development. It is likely that only fully established GCs, detectable on haematoxylin/eosin-stained samples, will correlate with the increased risk for lymphoma development, but this remains to be validated.
The generation or repurposing of biological therapies for the treatment of pSS has raised the possibility of using salivary gland biopsy analysis as an outcome measure of biological treatment efficacy. Whilst a general consensus on the standardised use of salivary gland biopsies as an outcome measure has not been achieved, several studies have already used this tool to monitor biological effects in the tissue.
Pijpe et al. (2009) reported the use of histological analysis to evaluate the efficacy of rituximab in pSS patients. Biopsies were taken prior to and 12 weeks after treatment. Together with the focus score, the authors considered the B/T cell ratio, the disappearance of the GC-like structures and the reduction of the infiltrating lymphocytes in the ducts, providing a comprehensive analysis of the spread and organisation of the infiltrate [41]. Another aspect considered in this analysis was the quantification of actively proliferating parenchyma and the evaluation of parenchyma/fat representation in the biopsies. Both these parameters are interesting and informative regarding potential mechanisms of action and biological activity of the compound under evaluation, but have not been used or validated as such in other cohorts. The same group has further exploited the use of salivary gland biopsy to monitor the biological response to rituximab in patients with parotid MALT lymphoma, proving the therapeutic effect of B cell depletion in this condition [42].
Carubbi et al. in 2013 also reported changes occurring in salivary gland lesions in 19 pSS patients treated with rituximab for 120 weeks [43]. Histological examination in this study included a measurement of the focus score (89.4% of patients presented a focus score below 1 by the end of the study) alongside data on the compartmentalisation of B and T cell areas and consequent formation of GC-like structures, the incidence of which was found to be significantly reduced (from 52.6% to 5.2% in the second biopsy) [43]. These data integrated previous reports from the same group [43], in which immunohistochemistry was used to investigate changes in CXCL12 and CXCL13 expression as well the percentage of CXCR4+ and CXCR5+ cells within the lymphocytic infiltrate after treatment.
In a pilot study in pSS patients treated with abatacept, Adler et al. expanded the histological analysis, in which they could not demonstrate a reduction of the focus score but found a total reduction in the number of the inflammatory foci, with a detailed report of the T cell infiltration [44].
A summary of the histological changes detected in these studies is reported in table 3.
| Table 3:Histological changes observed in the salivary glands following biological treatment. | |
| Measuring post-treatment lymphocytic aggregates in primary Sjögren’s syndrome | |
| Study | Histological findings |
| Rituximab for 12 weeks (Pijpe et al., 2009 [41]) | Reduced lymphocytic infiltration Decreased B/T cell ratio. Reduced numbers of germinal centre-like structures (absent in four out of five patients) Reduced number and size of lymphoepithelial sialadenitis (LESA) lesions Reduction in actively proliferating parenchyma No change in the amount of acinar parenchyma or fat |
| Rituximab for 120 weeks (Carubbi et al., 2013 [43]) | Reduced focus score (89.4% of patients with focus score <1) Reduced incidence of germinal centre-like structures (absent in 18 out of 19 patients) CXCL12, CXCL13 Reduced percentage of CXCR4+ and CXCR5+ cells in total mononuclear cell infiltrate |
| Abatacept for 24 weeks (Adler et al., 2013 [44]) | No difference in focus score Reduced number of lymphocytic foci (reduced numbers of B and T cells) Reduction in FoxP3+ T cells |
Other elements such as proteomic/seric biomarkers (in blood or saliva) and ultrasound examination of the glands also have the potential to be integrated with the information obtained by the histological examination. A recent publication looking at the proteomic profile of saliva clearly demonstrates the presence of a specific profile in patients with pSS (high levels of clusterin, IL-4, IL-5 and IL-6) [45]. Nonetheless, such analysis failed to stratify pSS patients with or without GC in the glands, and the authors suggested the possibility to overcome this problem by integrating the current platform with additional proteins [45]. Larger studies are therefore required to exploit this technique further. Similarly, great interest has arisen on the possibility to substitute histological assessment for the ultrasound evaluation. Whilst ultrasonography of the large salivary glands is seen as a functional, simple and well-tolerated tool to study parenchymal modifications in the glands [46], there is a lack of substantial evidence of its use in clinical trials to monitor changes upon intervention. At present, ultrasound is advisable to complement the histological analysis, rather than substitute it.
In conclusion, despite the lack of agreement in the parameters considered when evaluating salivary gland biopsies, histology remains the gold standard for diagnosis of pSS and has the potential to become the most reliable biomarker in clinical studies. However, the heterogeneity of the measurements might present the potential risk of compromising the combined analysis of different trials. This risk is increased when considering the lack of consensus on the minimal area to be analysed, the use of image analysis systems to quantify the surface area of the foci, the number of cutting levels to be evaluated and the potential use of immunohistochemistry to provide additional data on the degree of aggregate organisation. The current interest in designing clinical trials in pSS will therefore require a combined effort of rheumatologists and oral medicine specialists to discuss these aspects and define consensus guidelines on the methodology and use of the salivary gland biopsy analysis in clinical trials.
1 Chisholm DM, Mason DK. Labial salivary gland biopsy in Sjogren’s disease. J Clin Pathol. 1968;21(5):656–60.
2 Moutsopoulos HM. Sjogren’s syndrome: autoimmune epithelitis. Clin Immunol Immunopathol. 1994;72(2):162–5.
3 Bowman SJ, Ibrahim GH, Holmes G, Hamburger J, Ainsworth JR. Estimating the prevalence among Caucasian women of primary Sjogren's syndrome in two general practices in Birmingham, UK. Scand J Rheumatol. 2004;33(1):39–43.
4 Fox RI, Tornwall J, Michelson P. Current issues in the diagnosis and treatment of Sjogren’s syndrome. Curr Opinion Rheumatol. 1999;11(5):364–71.
5 Pillemer SR, Matteson EL, Jacobsson LT, Martens PB, Melton LJ, 3rd, W.M. O’Fallon, et al. Incidence of physician-diagnosed primary Sjogren syndrome in residents of Olmsted County, Minnesota. Mayo Clin Proc. 2001;76(6):593–9.
6 Shiboski SC, Shiboski CH, Criswell L, Baer A, Challacombe S, Lanfranchi H, et al. American College of Rheumatology classification criteria for Sjogren’s syndrome: a data-driven, expert consensus approach in the Sjogren’s International Collaborative Clinical Alliance cohort. Arthritis Care Res. 2012;64(4):475–87.
7 Anaya JM, Delgado-Vega AM, Castiblanco J. Genetic basis of Sjogren’s syndrome. How strong is the evidence? Clinical & developmental immunology. 2006;13(2-4):209–22.
8 Ramos-Casals M, Solans R, Rosas J, Camps MT, Gil A, Del Pino-Montes J, et al. Primary Sjogren syndrome in Spain: clinical and immunologic expression in 1010 patients. Medicine. 2008;87(4):210–9.
9 Malladi AS, Sack KE, Shiboski SC, Shiboski CH, Baer AN, Banushree R, et al. Primary Sjogren’s syndrome as a systemic disease: a study of participants enrolled in an international Sjogren’s syndrome registry. Arthritis Care Res. 2012;64(6):911–8.
10 Moutsopoulos HM, Manoussakis MN. Lumping or splitting autoimmune rheumatic disorders? Lessons from Sjogren’s syndrome. Br J Rheumatol. 1998;37(12):1263–4.
11 Theander E, Henriksson G, Ljungberg O, Mandl T, Manthorpe R, Jacobsson LT. Lymphoma and other malignancies in primary Sjogren’s syndrome: a cohort study on cancer incidence and lymphoma predictors. Ann Rheum Dis. 2006;65(6):796–803.
12 Voulgarelis M, Dafni UG, Isenberg DA, Moutsopoulos HM. Malignant lymphoma in primary Sjogren’s syndrome: a multicenter, retrospective, clinical study by the European Concerted Action on Sjogren’s Syndrome. Arthritis Rheum. 1999;42(8):1765–72.
13 Greenspan JS, Daniels TE, Talal N, Sylvester RA. The histopathology of Sjogren’s syndrome in labial salivary gland biopsies. Oral Surg Oral Med Oral Pathol. 1974;37(2):217–29.
14 Daniels TE, Cox D, Shiboski CH, Schiodt M, Wu A, Lanfranchi H, et al. Associations between salivary gland histopathologic diagnoses and phenotypic features of Sjogren’s syndrome among 1,726 registry participants. Arthritis Rheum. 2011;63(7):2021–30.
15 Pijpe J, Kalk WW, van der Wal JE, Vissink A, Kluin PM, Roodenburg JL, et al. Parotid gland biopsy compared with labial biopsy in the diagnosis of patients with primary Sjogren’s syndrome. Rheumatology. 2007;46(2):335–41.
16 Carbone A, Gloghini A, Ferlito A. Pathological features of lymphoid proliferations of the salivary glands: lymphoepithelial sialadenitis versus low-grade B-cell lymphoma of the malt type. Ann Otol Rhinol Laryngol. 2000;109(12 Pt 1):1170–5.
17 Barone F, Bombardieri M, Manzo A, Blades MC, Morgan PR, Challacombe SJ, et al. Association of CXCL13 and CCL21 expression with the progressive organization of lymphoid-like structures in Sjogren’s syndrome. Arthritis Rheum. 2005;52(6):1773–84.
18 Bombardieri M, Barone F, Humby F, Kelly S, McGurk M, Morgan P, et al. Activation-induced cytidine deaminase expression in follicular dendritic cell networks and interfollicular large B cells supports functionality of ectopic lymphoid neogenesis in autoimmune sialoadenitis and MALT lymphoma in Sjogren’s syndrome. J Immunol. 2007;179(7):4929–38.
19 Gonzalez S, Aguilera S, Alliende C, Urzua U, Quest AF, Herrera L, et al. Alterations in type I hemidesmosome components suggestive of epigenetic control in the salivary glands of patients with Sjogren’s syndrome. Arthritis Rheum. 2011;63(4):1106–15.
20 Christodoulou MI, Kapsogeorgou EK, Moutsopoulos HM. Characteristics of the minor salivary gland infiltrates in Sjogren’s syndrome. J Autoimm. 2010;34(4):400–7.
21 Christodoulou MI, Kapsogeorgou EK, Moutsopoulos NM, Moutsopoulos HM. Foxp3+ T-regulatory cells in Sjogren’s syndrome: correlation with the grade of the autoimmune lesion and certain adverse prognostic factors. Am J Pathol. 2008;173(5):1389–96.
22 Salomonsson S, Jonsson MV, Skarstein K, Brokstad KA, Hjelmstrom P, Wahren-Herlenius M, et al. Cellular basis of ectopic germinal center formation and autoantibody production in the target organ of patients with Sjogren’s syndrome. Arthritis Rheum. 2003;48(11):3187–201.
23 Ansel KM, Ngo VN, Hyman PL, Luther SA, Forster R, Sedgwick JD, et al. A chemokine-driven positive feedback loop organizes lymphoid follicles. Nature. 2000;406(6793):309–14.
24 Luther SA, Tang HL, Hyman PL, Farr AG, Cyster JG. Coexpression of the chemokines ELC and SLC by T zone stromal cells and deletion of the ELC gene in the plt/plt mouse. Proc Natl Acad Sci U S A. 2000;97(23):12694–9.
25 Luther SA, Bidgol A, Hargreaves DC, Schmidt A, Xu Y, Paniyadi J, et al. Differing activities of homeostatic chemokines CCL19, CCL21, and CXCL12 in lymphocyte and dendritic cell recruitment and lymphoid neogenesis. J Immunol. 2002;169(1):424–33.
26 Mebius RE. Organogenesis of lymphoid tissues. Nature reviews. Immunology. 2003;3(4):292–303.
27 Barone F, Bombardieri M, Rosado MM, Morgan PR, Challacombe SJ, De Vita S, et al. CXCL13, CCL21, and CXCL12 expression in salivary glands of patients with Sjogren’s syndrome and MALT lymphoma: association with reactive and malignant areas of lymphoid organization. J Immunol. 2008;180(7):5130–40.
28 Vitali C, Bombardieri S, Moutsopoulos HM, Coll J, Gerli R, Hatron PY, et al. Assessment of the European classification criteria for Sjogren’s syndrome in a series of clinically defined cases: results of a prospective multicentre study. The European Study Group on Diagnostic Criteria for Sjogren’s Syndrome. Ann Rheum Dis. 1996;55(2):116–21.
29 Vitali C, Bombardieri S, Jonsson R, Moutsopoulos HM, Alexander EL, Carsons SE, et al. Classification criteria for Sjogren’s syndrome: a revised version of the European criteria proposed by the American-European Consensus Group. Ann Rheum Dis. 2002;61(6):554–8.
30 Rasmussen A, Ice JA, Li H, Grundahl K, Kelly JA, Radfar L, et al. Comparison of the American-European Consensus Group Sjogren’s syndrome classification criteria to newly proposed American College of Rheumatology criteria in a large, carefully characterised sicca cohort. Ann Rheum Dis. 2014;73(1):31–8.
31 Giovelli RA, Santos MC, Serrano EV, Valim V. Clinical characteristics and biopsy accuracy in suspected cases of Sjogren’s syndrome referred to labial salivary gland biopsy. BMC Musculoskelet Disord. 2015;16:30.
32 Colella G, Cannavale R, Vicidomini A, Itro A. Salivary gland biopsy: a comprehensive review of techniques and related complications. Rheumatol. 2010;49(11):2117–21.
33 Gerli R, Muscat C, Giansanti M, Danieli MG, Sciuto M, Gabrielli A, et al. Quantitative assessment of salivary gland inflammatory infiltration in primary Sjogren’s syndrome: its relationship to different demographic, clinical and serological features of the disorder. Br J Rheumatolo. 1997;36(9):969–75.
34 Haldorsen K, Moen K, Jacobsen H, Jonsson R, Brun JG. Exocrine function in primary Sjogren syndrome: natural course and prognostic factors. Ann Rheum Dis. 2008;67(7):949–54.
35 Risselada AP, Kruize AA, Bijlsma JW. Clinical features distinguishing lymphoma development in primary Sjogren’s Syndrome – a retrospective cohort study. Sem Arthritis Rheum. 2013;43(2):171–7.
36 Costa S, Quintin-Roue I, Lesourd A, Jousse-Joulin S, Berthelot JM, Hachulla E, et al. Reliability of histopathological salivary gland biopsy assessment in Sjogren’s syndrome: a multicentre cohort study. Rheumatology. 2015;54(6):1056–64.
37 Morbini P, Manzo A, Caporali R, Epis O, Villa C, Tinelli C, et al. Multilevel examination of minor salivary gland biopsy for Sjogren’s syndrome significantly improves diagnostic performance of AECG classification criteria. Arthritis Res Ther. 2005;7(2):R343–8.
38 Risselada AP, Looije MF, Kruize AA, Bijlsma JW, van Roon JA. The role of ectopic germinal centers in the immunopathology of primary Sjogren’s syndrome: a systematic review. Semin Arthritis Rheum. 2013;42(4):368–76.
39 Theander E, Vasaitis L, Baecklund E, Nordmark G, Warfvinge G, Liedholm R, et al. Lymphoid organisation in labial salivary gland biopsies is a possible predictor for the development of malignant lymphoma in primary Sjogren’s syndrome. Ann Rheum Dis. 2011;70(8):1363–8.
40 Fox RI. The importance of minor salivary gland biopsy in prediction of lymphoma in Sjogren’s syndrome: should we be obtaining more information about prognosis from minor salivary gland samples? Ann Rheum Dis. 2011;70(8):1351–3.
41 Pijpe J, Meijer JM, Bootsma H, van der Wal JE, Spijkervet FK, Kallenberg CG, et al. Clinical and histologic evidence of salivary gland restoration supports the efficacy of rituximab treatment in Sjogren’s syndrome. Arthritis Rheum. 2009;60(11):3251–6.
42 Pijpe J, van Imhoff GW, Vissink A, van der Wal JE, Kluin PM, Spijkervet FK, et al. Changes in salivary gland immunohistology and function after rituximab monotherapy in a patient with Sjogren’s syndrome and associated MALT lymphoma. Ann Rheum Dis. 2005;64(6):958–60.
43 Carubbi F, Cipriani P, Marrelli A, Benedetto P, Ruscitti P, Berardicurti O, et al. Efficacy and safety of rituximab treatment in early primary Sjogren’s syndrome: a prospective, multi-center, follow-up study. Arthritis Res Ther. 2013;15(5):R172.
44 Adler S, Korner M, Forgerv, Huscher D, Caversaccio MD, Villiger PM. Evaluation of histologic, serologic, and clinical changes in response to abatacept treatment of primary Sjogren’s syndrome: a pilot study. Arthritis Care Res. 2013;65(11):1862–8.
45 Delaleu N, Mydel P, Kwee I, Brun JG, Jonsson MV, Jonsson R. High fidelity between saliva proteomics and the biologic state of salivary glands defines biomarker signatures for primary Sjogren’s syndrome. Arthritis Rheum. 2015;67(4):1084–95.
46 Carotti M, Ciapetti A, Jousse-Joulin S, Salaffi F. Ultrasonography of the salivary glands: the role of grey-scale and colour/power Doppler. Clin Exp Rheumatol. 2014;32(1 Suppl 80):S61–70.
47 Kramer JM, Klimatcheva E, Rothstein TL. CXCL13 is elevated in Sjogren's syndrome in mice and humans and is implicated in disease pathogenesis. J Leukocyte Biol. 2013;94(5):1079–89.
48 Bowman SJ, Fox RI. Classification criteria for Sjogren's syndrome: nothing ever stands still! Ann Rheum Dis. 2014;73(1):1–2.
49 Fisher BA, Brown RM, Bowman SJ, Barone F. A review of salivary gland histopathology in primary Sjogren's syndrome with a focus on its potential as a clinical trials biomarker. Ann Rheum Dis. 2015;74(9):1645–50.
50 Waterhouse JP, Doniach I. Post-mortem prevalence of focal lymphocytic adenitis of the submandibular salivary gland. J Pathol Bacteriol. 1966;91(1):53–64.
Disclosures: No financial support and no other potential conflict of interest relevant to this article was reported.